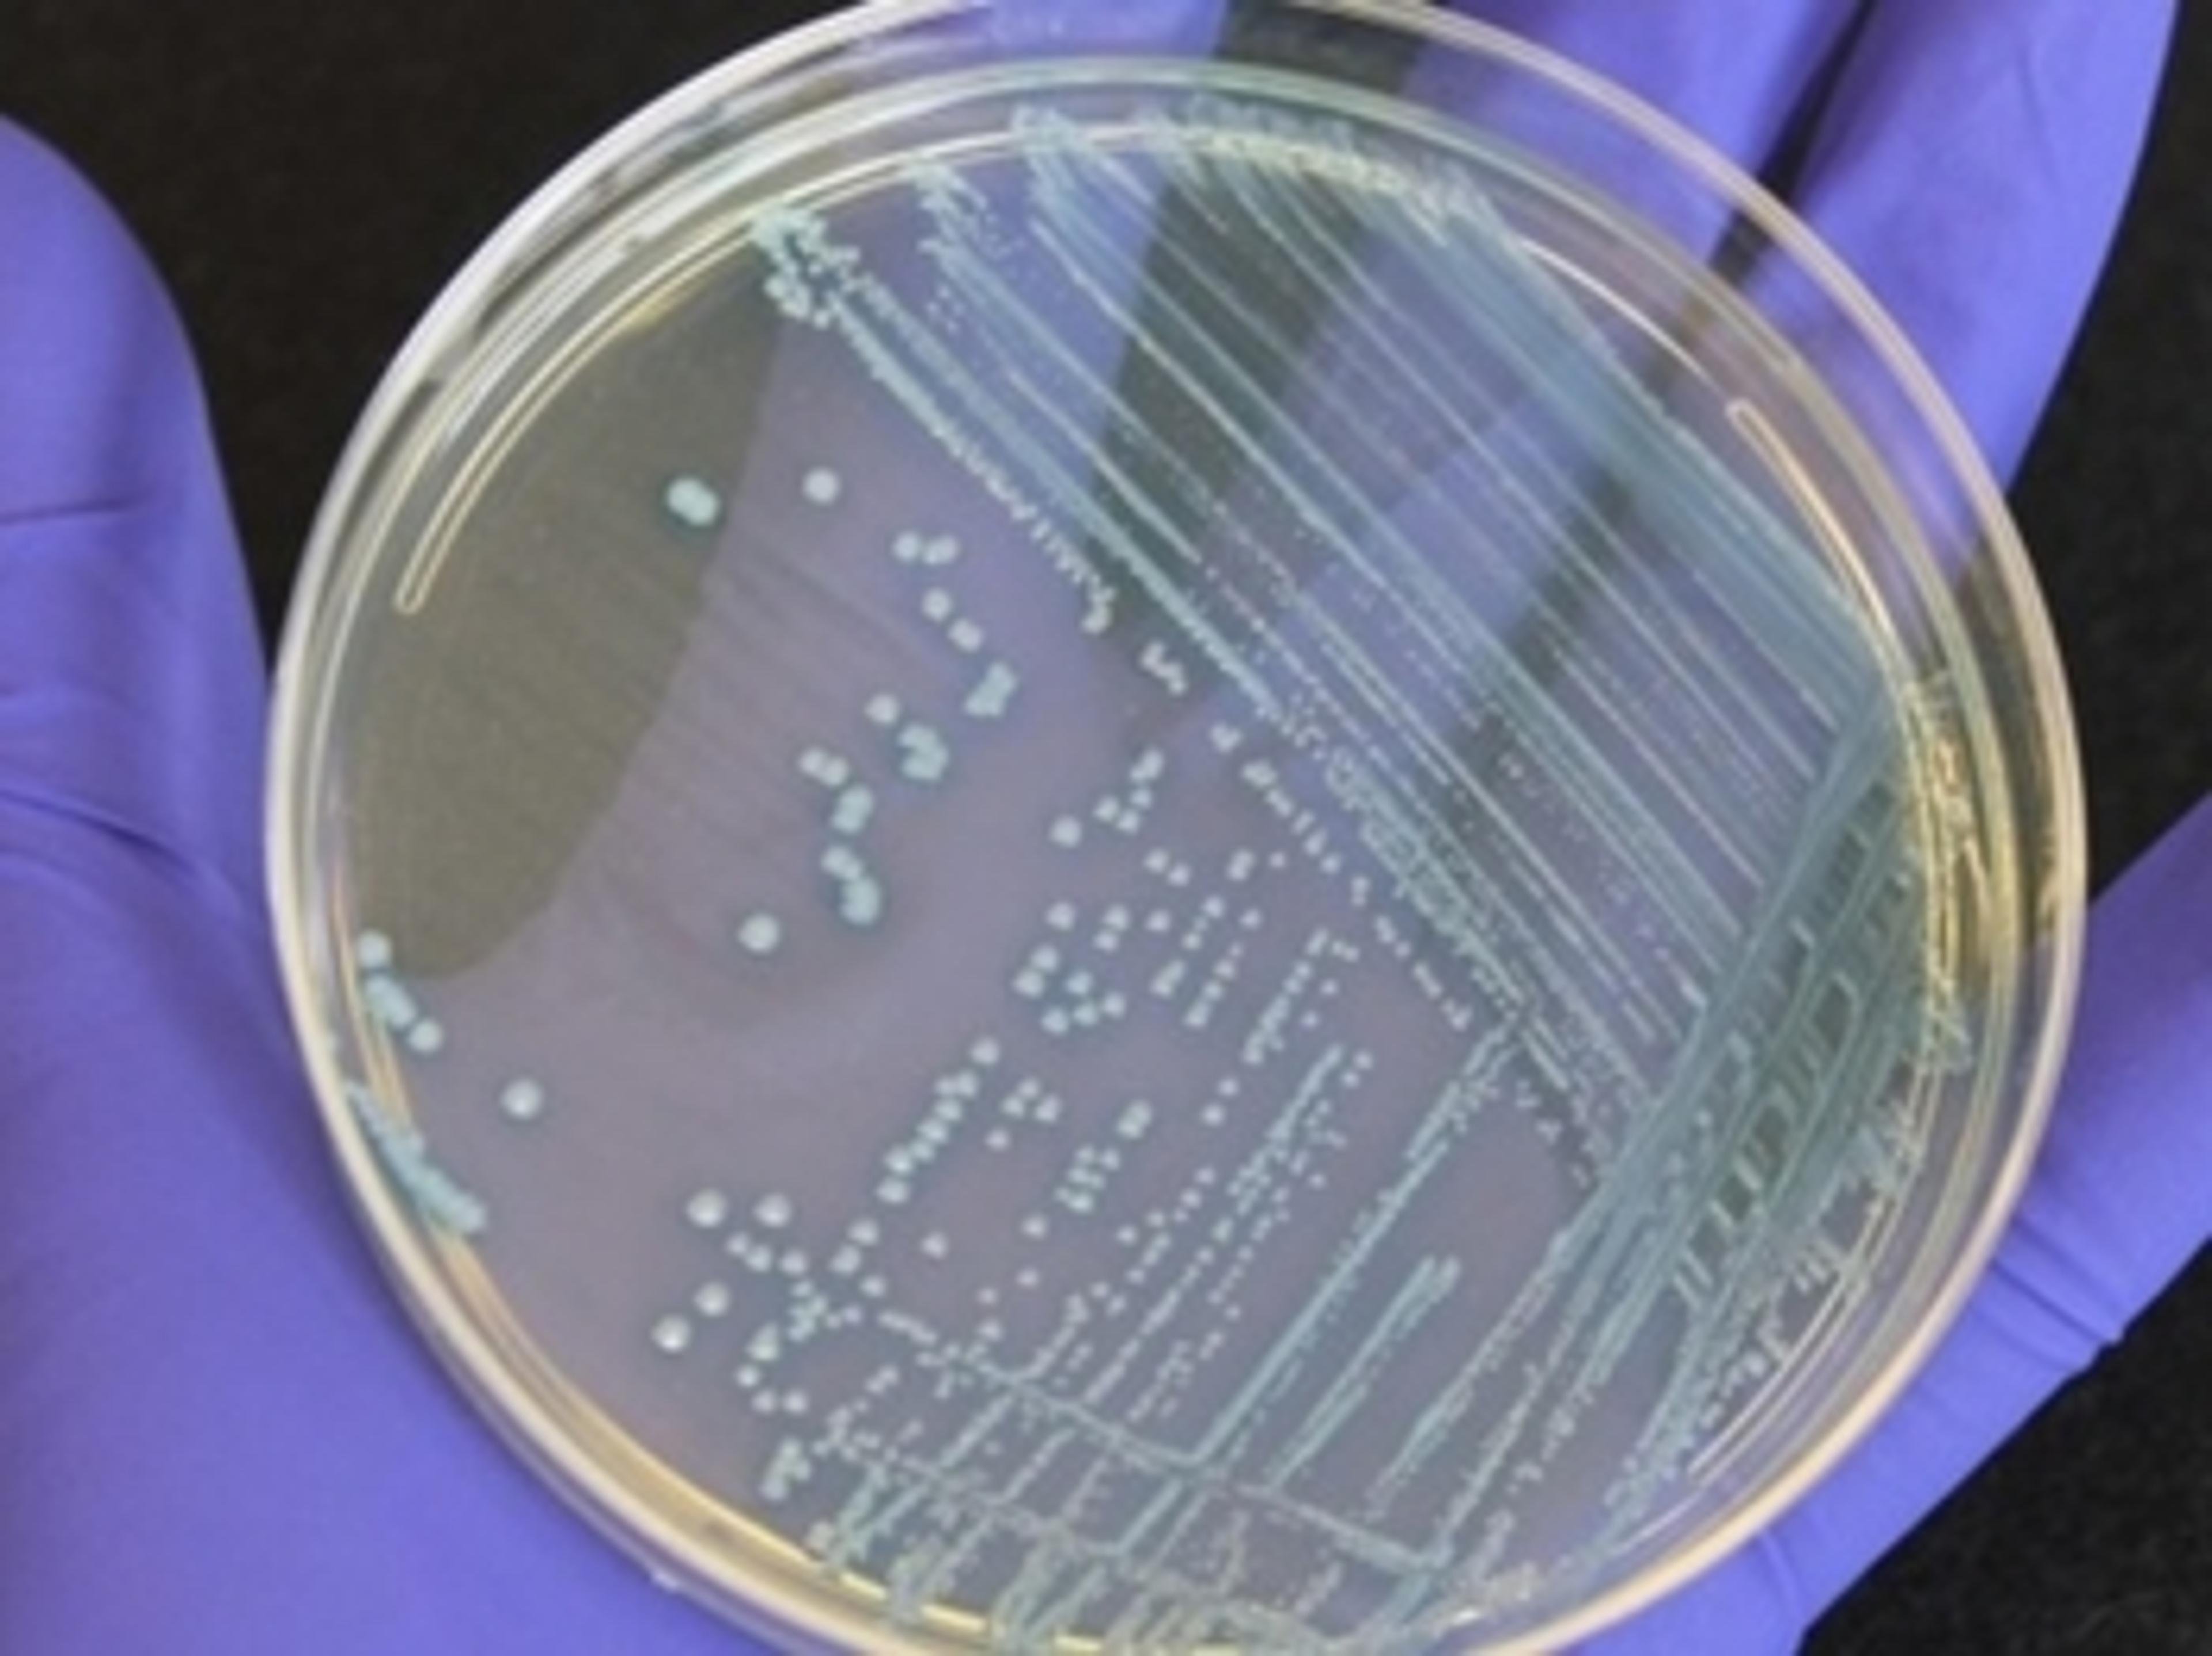

News & Articles
New industrial partnership aims to make plant-based food taste better
The partnership’s mission is to better understand the impact of saliva on how we perceive taste and texture during chewing
Food science researchers advance science behind gut health and prebiotics
The results of this research have implications for human health beyond digestion and gut health
Roche launches comprehensive genomic profiling kit to expand access to personalized cancer research
The AVENIO Tumor Tissue Comprehensive Genomic Profiling Kit is the first jointly-developed product that brings together the expertise and reach of Roche with Foundation Medicine’s pioneering leadership in genomic science
Novel athermalized reflective beam collimator
Global pharmaceutical company proves validity of AI in life sciences through Pangaea Data’s novel Natural Language Generation driven product
Leading global pharmaceutical company presented Pangaea Data’s Novel AI to automatically generate textual clinical narratives for regulatory reports
New generation M320 surgical microscope for ENT from Leica Microsystems
The 4K camera in ENT microscope supports patient communication
Reducing off-target effects in RNA interference experiments
In this article, Dr. Christian Nievera, senior product manager at Horizon Discovery, discusses how to minimize non-specific effects of siRNA reagents
CHOSOURCE™ Platform expanding to include CHO-K1 ADCC+ expression cell line
Existing CHO platform, featuring low cost and no royalty or license tie-ins, expands with new cell line to help develop biotherapeutics
Here’s how experts are breaking down barriers in flow cytometry
A flow cytometry technician shares how live high-speed image capture increases the range of information obtained from limited sample materials
‘To evolve great concepts we need to be able to communicate effectively’
Clinical scientist Dr. Guy-Armel Bounda discusses the importance of reviews in providing true, unbiased feedback when looking for research equipment
Increasing CRISPR editing efficiency with novel guide RNA methods
Watch this on-demand webinar to discover recent technological advances in CRISPR/Cas gene editing
SPT Labtech integrates recent acquisitions into unified brand and portfolio
New branding brings together SPT Labtech’s technologies with those from recent acquisitions into a single entity
Roche’s VENTANA PD-L1 Assay receives FDA approval as a companion diagnostic to identify lung cancer patients eligible for Tecentriq (atezolizumab)
The VENTANA PD-L1 (SP263) Assay helps determine which non-small cell lung cancer patients may benefit from treatment with Tecentriq immunotherapy based on the results of the Phase III IMpower010 study
68 U.S. forensic labs now using STRmix to interpret complex DNA profiles
Phoenix PD Crime Lab is latest to employ software to examine forensic evidence
How to optimize your cell-based assays: Overcoming common challenges
Cell culture expert Ann-Cathrin Volz discusses current trends and challenges in the field and shares a solution
Food fraud & food safety: Top trending videos
Watch exclusive interviews with industry experts on the power of NGS in ensuring the safety of food products
Detect, discover, diagnose: Uncovering biomarkers to advance non-invasive breath-based diagnostics
Watch this free on-demand webinar to discover how headspace analytical methods are being utilized in the detection of volatile biomarkers
TrueMass presents first commercial CDMS instrument to support analysis of macromolecules
Charge detection mass spectrometry adds new value to traditional mass spectrometry in detecting larger molecules such as coronaviruses.
Meet the ‘superhero’ on a mission to make labs safer across the world
We hear from Dan Scungio on the critical importance of effective biosafety practices, as illustrated by the COVID-19 pandemic
6 webinars to take your research to the next level
Gain insights on topics from laboratory ergonomics, quality control, cell counting, mRNA vaccines, and more
Verogen partners with Cellmark Forensic Services to launch UK’s first ISO17025 accredited forensic next-generation sequencing service
The collaboration aims to enable the resolution of challenging forensic investigations and complex relationship cases